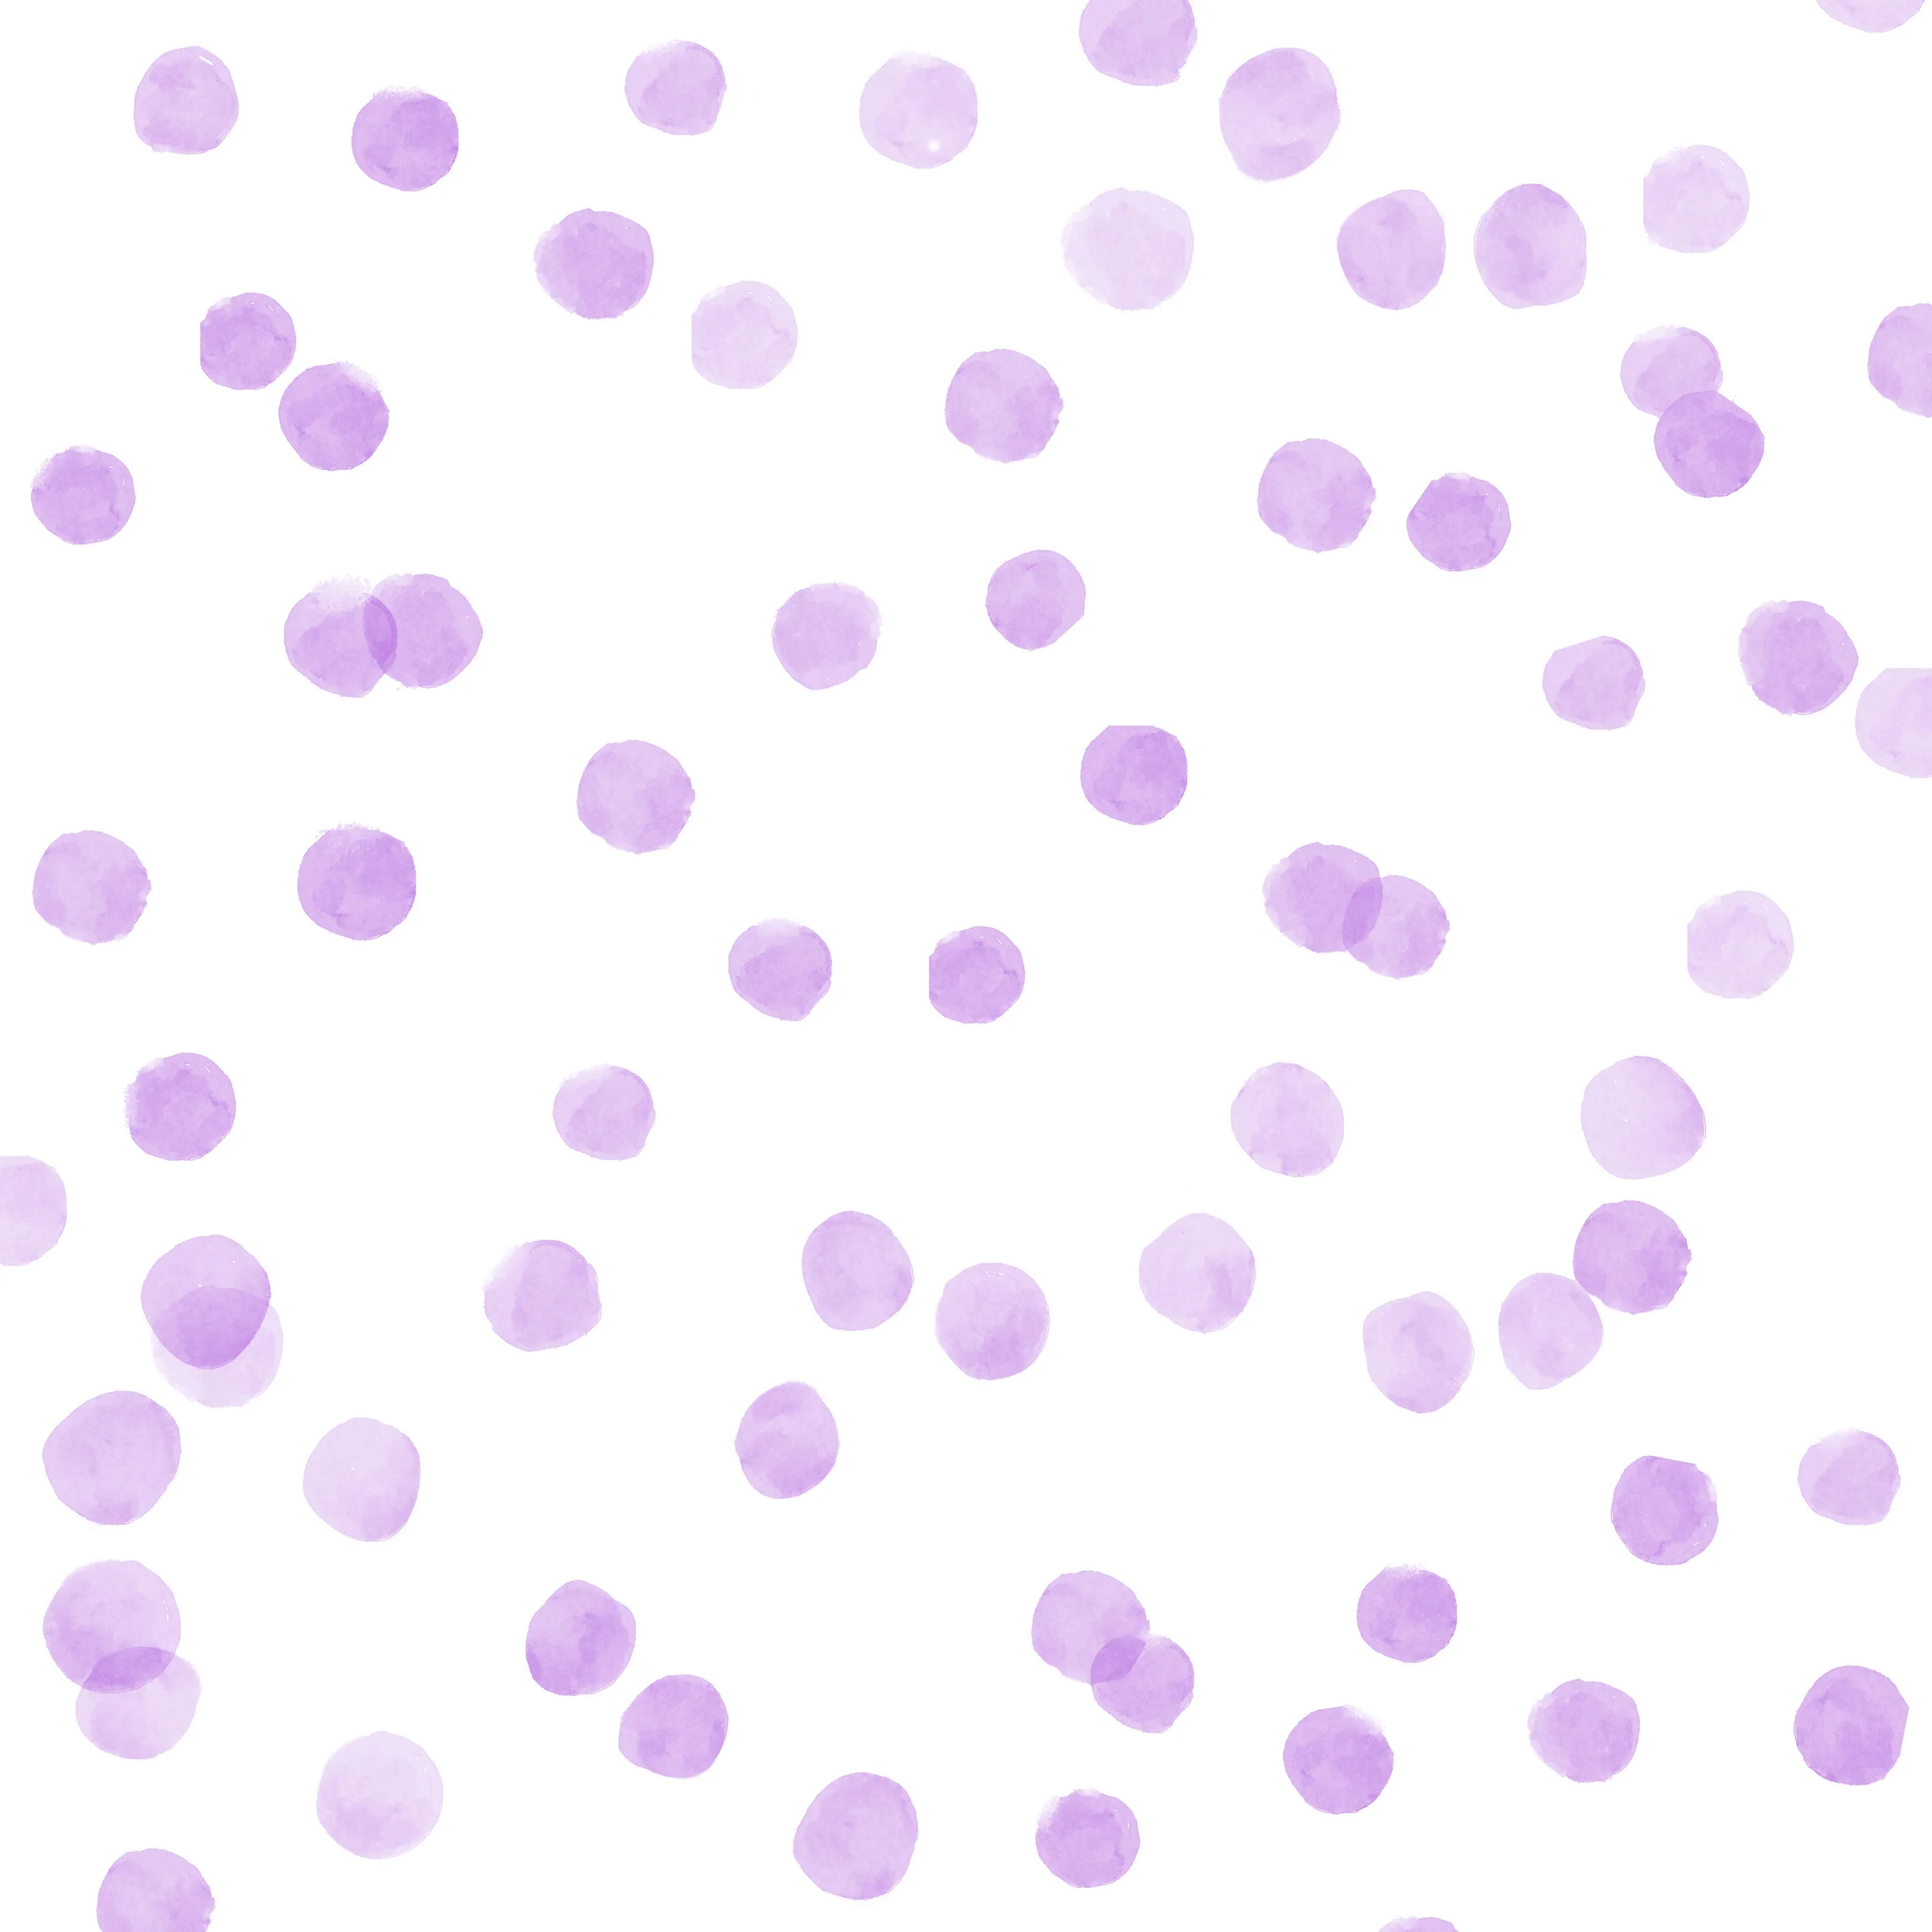

Previous
Previous
SIMPLE DESIGN | Changing Colors in PS
Next
Next

Fresh, colorful and contemporary elements are applied to all of my projects. With 10+ years of creative experience, I have produced innovative designs and unique marketing collateral. I create strategic content, push social media platforms and
construct hype that can generate leads. I am detail oriented, work well in or leading groups to achieve success and enjoy a challenge. I adore travel. You will often find me hiking, running, biking, doing yoga or swimming with my pup and camera in tow.